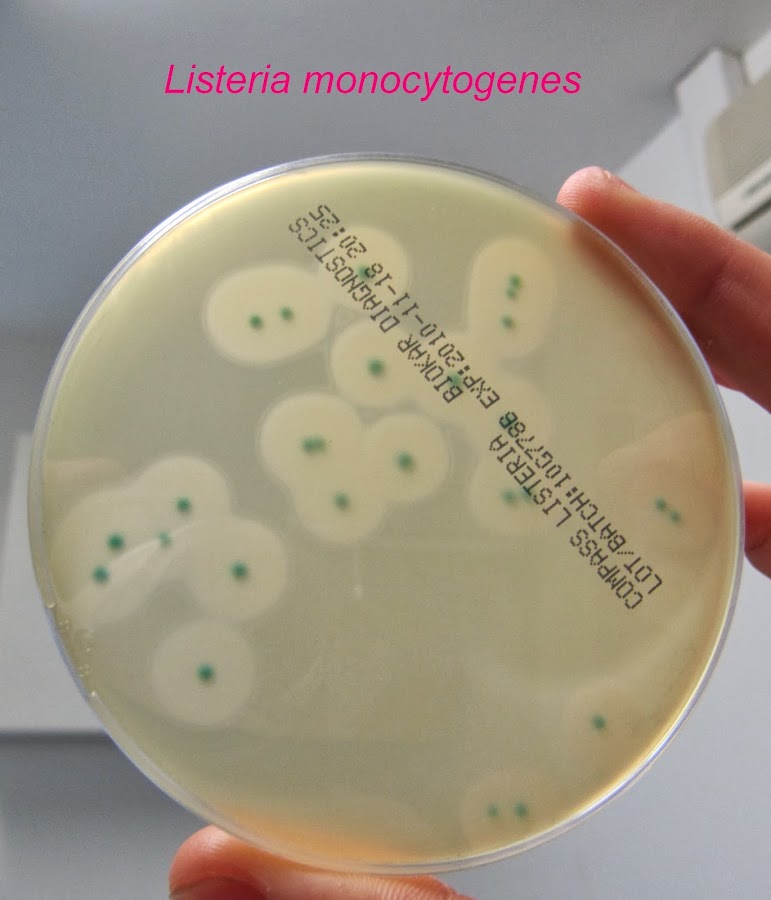

Napoleón Bonaparte
Análisis de riesgos y peligros microbiológicos en alimentos (2da y última parte)
A continuación, propondremos 3 (tres) ejemplos desarrollados, que fueran oportunamente elaborados por la FAO (ONU) para bacterias símbolo en todo el mundo, sobre contaminación: Salmonella y Listeria; por último, para el caso de los parásitos, se analizará el accionar de Anisakis dentro de la investigación epidemiológica.
CRITERIO MICROBIOLOGICO para SALMONELLA en HUEVOS de CONSUMO
Como factores determinantes de los casos de salmonelosis humanas asociados a huevos y ovoproductos hay que considerar los múltiples factores que condicionan la probabilidad de que los huevos, sea a nivel interno o externamente, estén contaminados con Salmonella al final del proceso de producción en granja. Entre ellos adquieren especial relevancia la prevalencia de granjas con aves portadoras de Salmonella, la de aves contaminadas en cada granja, el número de salmonellas excretadas por las aves, la frecuencia de huevos contaminados internamente en el momento de la puesta, el sistema de producción, la calidad bacteriológica del agua y piensos (o materias primas para piensos), así como las condiciones higiénicas de la granja y de los procesos de recogida, clasificación y manipulación de los huevos. Los que condicionan la persistencia y/o multiplicación de Salmonella en los sustratos alimenticios durante los procesos de conservación y procesado de los huevos (principalmente factores intrínsecos –propiedades del sustrato-, factores extrínsecos –temperatura y tiempo de conservación – y tipo e intensidad de los tratamientos tecnológicos aplicados –esencialmente, intensidad del tratamiento térmico).
Los que condicionan la contaminación durante los procesos de preparación culinaria de productos derivados del huevo (principalmente, contaminación cruzada). La contaminación exógena procedente de los manipuladores en cualquiera de las etapas de la cadena producción-consumo (especialmente en las etapas de preparación previa al consumo). El análisis microbiológico de los productos alimenticios antes de su consumo, incluso cuando se lleva a cabo con la aplicación de principios científicos sólidamente establecidos, no informa con razonable eficacia de su seguridad para el consumo. El reconocimiento de tal limitación ha determinado la sustitución paulatina de las normas microbiológicas de producto final por: (1) la implantación obligatoria de buenas prácticas higiénicas de obtención, elaboración, transporte, distribución, preparación para el consumo y venta de productos alimenticios, y (2) la obligatoriedad de utilización por los explotadores alimentarios de un sistema preventivo basado en el control de los procesos (actualmente, el sistema HACCP -Hazard Analysis and Critical Control Points- ó APPCC -Análisis de Peligros y Puntos de Control Crítico).
Sin embargo, aún con las limitaciones antes señaladas, los análisis microbiológicos de los productos alimenticios constituyen una herramienta necesaria para aproximarse al conocimiento del estatus sanitario de alimentos, para los que no se dispone de información acerca de las condiciones de elaboración. Los criterios microbiológicos pueden adoptarse con una doble finalidad: como criterios de seguridad alimentaria o como criterios de higiene de los procesos. En relación con los huevos frescos, si bien el recuento de mesófilos aerobios y de bacterias Gram-negativas pudiera ser utilizado para evaluar los puntos de la cadena de procesado que proporcionan una mayor contaminación, no se dispone de información suficiente que permita relacionar el nivel de contaminación con estos microorganismos indicadores con la presencia de Salmonella.
En consecuencia, en términos de seguridad alimentaria, el criterio debería establecer como parámetro microbiológico el propio peligro (Salmonella). Basándose en el esquema de decisión sugerido por la ICMSF para la selección de un plan de muestreo a aplicar en un caso concreto (considerando la peligrosidad del microorganismo y la probabilidad de que la cuantía del mismo aumente o no antes del consumo del producto), para Salmonella en huevos frescos correspondería el caso 11, para el que la ICMSF sugiere un valor de n = 10 y de c= 0. Según dicho plan, se aceptan los lotes en los que en ninguna de las 10 unidades de muestra analizadas se detecta Salmonella.
CONTROL de LISTERIA MONOCYTOGENES en ALIMENTOS
Listeria monocytogenes es una bacteria Gram positiva que se encuentra ampliamente distribuida tanto en el medio agrario (suelo, plantas, forraje en silos, materia fecal, aguas residuales, agua), como en la acuicultura y los ambientes de elaboración de alimentos. L. monocytogenes es un residente intestinal transitorio en los seres humanos; entre el 2 por ciento y el 10 por ciento de la población en general es portador de este microorganismo sin con-secuencias evidentes para la salud. Comparada con otras bacterias patógenas que no producen esporas y que son transmitidas por los alimentos (Salmonella spp., Escherichia coli enterohemorrágica), L. monocytogenes es resistente a varias condiciones medioambientales tales como altas concentraciones de sal o acidez. Asimismo, crece en condiciones de baja concentración de oxígeno y a temperaturas de refrigeración y sobrevive por largos períodos en el medio ambiente, en los alimentos, en las plantas de elaboración y en el refrigerador doméstico.
L. Monocytogenes se ha aislado en alimentos tales como las hortalizas crudas, la leche cruda y la leche líquida pasteurizada, los quesos (en especial, las variedades blandas y curadas), el helado, la mantequilla, los embutidos de carne cruda fermentados, la carne aviar cruda y cocida, las carnes crudas y elaboradas (de todos los tipos) y el pescado crudo, conservado y ahumado. Incluso cuando L. monocytogenes está presente inicialmente en cantidades pequeñas en un alimento contaminado, el microorganismo podría multiplicarse durante el almacenamiento en los alimentos que brindan condiciones óptimas para su proliferación, incluso a temperaturas de refrigeración. La listeriosis es una infección que afecta con mayor frecuencia a personas inmunocomprometidas. Durante los últimos años, la frecuencia de la listeriosis se ha mantenido constante en la mayoría de los países; varios países han informado una reducción en la frecuencia de los casos.
Esta disminución muy probablemente refleja los esfuerzos realizados en esos países por la industria y los gobiernos para a) aplicar las “buenas prácticas de higiene” (BPH) y el sistema de APPCC, a fin de reducir la frecuencia y el alcance de L. monocytogenes en los alimentos listos para el consumo, b) mejorar la integridad de la cadena del frío a lo largo de la elaboración, la distribución, las ventas al por menor y en los hogares, con el fin de reducir la frecuencia del uso de las temperaturas indebidas que fomentan la proliferación de L. monocytogenes, y c) mejorar la comunicación de riesgos, en particular para los consumidores que tienen un riesgo mayor de contraer listeriosis. Por lo general, una combinación de intervenciones es más eficaz que cualquier intervención aislada para controlar el riesgo. El control de la proliferación puede lograrse mediante distintos métodos, entre ellos la reformulación del producto de manera que se alteren uno o más de los parámetros que influyen en la proliferación de la bacteria (pH, la actividad acuosa, la presencia de compuestos inhibitorios, etc.) a fin de que el alimento deje de actuar como el medio óptimo para su proliferación.
Por otra parte, el control riguroso de la temperatura de manera que los alimentos listos para el consumo nunca superen los 6°C (preferentemente de 2°C - 4°C) y/o la reducción de la vida útil del producto en condiciones de refrigeración o de frío son otros modos de asegurar que la proliferación no se produzca a un grado significativo antes del consumo del producto. La producción de muchos de los productos listos para el consumo asociados con la listeriosis transmitida por los alimentos prevé una fase bactericida. Por consiguiente, la frecuencia y el grado de contaminación de estos productos con L. monocytogenes están típicamente relacionados con la recontaminación del producto antes del envasado final o con la manipulación ulterior durante su comercialización o uso en el hogar. Muchos de los alimentos listos para el consumo son sometidos a uno o más tratamientos durante la elaboración o la preparación, que inactivan o inhiben la proliferación de L. monocytogenes. En el caso de estos alimentos, la sanidad animal y la aplicación general de las buenas prácticas agrícolas, incluidas las prácticas pecuarias, deberían ser suficientes para reducir al mínimo la prevalencia de L. monocytogenes en la producción primaria.
El equipo y las instalaciones deberían diseñarse, construirse y proyectarse de manera que se asegure que se permita la realización adecuada de la limpieza y se reduzca al mínimo la posible existencia de lugares donde pueda anidarse L. monocytogenes, así como la posibilidad de contaminación cruzada y recontaminación. La introducción de L. monocytogenes en el ambiente de elaboración de los alimentos listos para el consumo ha derivado de la separación insuficiente de la zona de productos crudos de la zona de productos terminados, así como del control deficiente de la circulación de empleados o equipos. La incapacidad de limpiar y desinfectar debidamente el equipo y los edificios debido a una disposición o diseño deficiente y a la existencia de zonas inaccesibles para la limpieza ha creado biofilms que contienen L. monocytogenes y sitios de anidamiento, que han sido fuentes de contaminación del producto. La incapacidad de controlar debidamente la ventilación para reducir al mínimo la condensación sobre las superficies en las plantas elaboradoras de alimentos puede dar lugar a la presencia de L. monocytogenes en gotitas y aerosoles, que a su vez puede causar la contaminación del producto.
Siempre que sea factible, los locales y las salas deberían diseñarse de manera que exista una separación entre las zonas para productos crudos y las zonas para productos terminados listos para el consumo. Esto puede lograrse de varias maneras, incluso mediante el flujo lineal del producto (de crudo a terminado) con filtración del flujo del aire en dirección opuesta (de productos terminados a crudos) o mediante separaciones físicas. Se debería mantener una presión positiva del aire en el sector de los productos terminados en relación con la zona de productos crudos (mantener las presiones de aire más bajas en las zonas de productos crudos y más altas en las zonas de productos terminados). Cuando sea factible, las zonas de lavado del equipo alimentario utilizado en la elaboración del producto terminado deberían ubicarse en una sala separada de la zona de elaboración del producto terminado. Esta última debería estar separada de la zona de manipulación de materias primas y de la zona de limpieza del equipo utilizado en la manipulación de la materia prima, a fin de impedir la recontaminación del equipo y de los utensilios empleados en los productos terminados.
Las salas donde los productos listos para el consumo están expuestos al medioambiente deberían diseñarse de manera que se puedan conservar lo más secas posible; las operaciones húmedas con frecuencia aumentan la proliferación y la propagación de L. monocytogenes. Debido a la capacidad de L. monocytogenes de sobrevivir en biofilms y en sitios anidamiento durante períodos largos, el equipo de elaboración debería diseñarse, construirse y mantenerse de manera que se eviten, por ejemplo, grietas, hendiduras, soldaduras ásperas, tubos y soportes huecos, montajes próximos de superficies de metal a metal o de metal a plástico, cierres y juntas estropeados u otras zonas que no pueden alcanzarse durante la labor normal de limpieza y desinfección de las superficies y zonas adyacentes que entran en contacto con los alimentos. Las superficies frías (p. ej., los refrigeradores) pueden ser fuentes de bacterias psicrótrofas, especialmente de L. monocytogenes. La condensación de las bandejas de los refrigeradores debería dirigirse a un desaguadero mediante una manguera o se deberían vaciar, limpiar y desinfectar las bandejas de goteo con regularidad. La vigilancia y el control de las temperaturas de almacenamiento refrigerado son medidas de control fundamentales. La temperatura del producto no debería superar los 6°C (preferentemente 2°C - 4°C).
La exposición a temperaturas indebidas que pudieran favorecer la proliferación de L. monocytogenes podría determinar una reducción de la vida útil del producto. En algunos productos se podrá tomar como base uno de los parámetros siguientes: un pH inferior a 4,4, una actividad acuosa inferior a 0,92 o la congelación, para impedir la proliferación de L. monocytogenes. En otros productos se utiliza una combinación de parámetros. La validación debería realizarse para asegurar la eficacia de estos parámetros en situaciones donde se depende de combinaciones de parámetros o condiciones bacteriostáticas. Los productos que favorecen la proliferación de L. monocytogenes, que han sido sometidos a una fase listericida, pueden contaminarse o recontaminarse antes del envasado final. En estos casos, si fuera necesario, se podrían aplicar medidas de control adicionales (por ejemplo, la congelación del producto, la determinación de una vida útil más breve, la reformulación del producto) para limitar el grado de proliferación de L. monocytogenes o impedirla. Por otra parte, tal vez sea necesario un tratamiento listericida posterior al envasado (tratamiento térmico, de alta presión, o de irradiación, donde esté aceptado). El programa de mantenimiento preventivo debería incluir la sustitución o reparación programadas del equipo antes de que éste se convierta en una fuente de contaminación.
El equipo debería ser inspeccionado periódicamente para ver si hay piezas que estén agrietadas, desgastadas o donde se hayan creado espacios donde puedan acumularse alimentos y humedad (es decir, lugares de anidamiento). El mantenimiento preventivo debería incluir el examen y el mantenimiento periódicos de las cintas transportadoras, los filtros, las juntas, las bombas, el equipo de rebanado, llenado y envasado. Los filtros de aire utilizados para aspirar aire del exterior al interior de la planta deberían ser examinados y reemplazados según las especificaciones del fabricante o con mayor frecuencia, tomando como base la diferencia de presión o la vigilancia microbiológica. La experiencia indica que la excesiva dependencia de los productos químicos solamente para la limpieza puede conducir a un aumento de los niveles de contaminación microbiana. Los productos químicos para la limpieza deben aplicarse en la concentración de uso recomendada, durante un tiempo suficiente, a la temperatura recomendada y con la suficiente fuerza para eliminar la tierra y el biofilm.
Se han registrado casos de contaminación con L. Monocytogenes relacionados, en particular, con un fregado manual insuficiente durante el proceso de limpieza. Los consumidores deberían tener los suficientes conocimientos sobre L. monocytogenes y la higiene de los alimentos de manera que:
• entiendan la importancia de la vida útil, las fechas límite de venta o de uso escritas en la etiqueta de los alimentos;
• puedan realizar una elección con conocimiento de causa que sea apropiada para cada persona según su estado de salud y su correspondiente riesgo de contraer la listeriosis por transmisión alimentaria;
• impidan la contaminación con L. monocytogenes y su proliferación o supervivencia mediante el almacenamiento y la preparación adecuados de los alimentos listos para el consumo.
La evaluación de riesgos microbiológicos (ERM) puede considerarse un instrumento aplicable en la gestión de los riesgos ocasionados por los patógenos transmitidos por alimentos y en la elaboración de normas para el comercio internacional de productos alimenticios. No obstante, se reconoce que la realización de una ERM, particularmente de tipo cuantitativo, es una actividad que consume abundantes recursos y exige un enfoque multidisciplinario. La mayoría de los casos de listeriosis en personas son esporádicos o se enmarcan en brotes cuya delimitación geográfica, o temporal, o ambas, es generalmente difusa. Aunque la transmisión de L. monocytogenes puede ser vertical (de madre a hijo), zoonótica (de animal a persona) o nosocomial (contraída en un hospital), la importancia de los alimentos como vía primaria de transmisión a las personas de L. monocytogenes no se reconoció hasta la década de 1980, cuando se produjeron, en Norteamérica y Europa, varias grandes epidemias de listeriosis de origen común.
Los alimentos más frecuentemente asociados con listeriosis en seres humanos incluyen los alimentos listos para su consumo (LPC) de elaboración industrial con las siguientes características: i) sustentan la proliferación de L. monocytogenes, ii) su vida útil en refrigeración recomendada es prolongada, y iii) se consumen sin someterlos a tratamientos listericidas adicionales, por ejemplo el cocinado. A pesar de que son muchos y diversos los alimentos que pueden contaminarse con L. monocytogenes, las epidemias y casos esporádicos de listeriosis están predominantemente asociados a alimentos LPC (FDA/FSIS, 2001), una categoría grande y heterogénea de productos alimenticios que puede dividirse en muchos subgrupos diferentes. Según la definición del Códex (CAC, 1999b), los alimentos LPC comprenden cualquier alimento (incluidas las bebidas) que se consume normalmente en crudo y cualquier alimento manipulado, elaborado, mezclado, cocinado o transformado de otro modo en un tipo de alimento que se consume normalmente sin elaboración adicional.
La leche pasterizada es un alimento muy consumido, y su frecuencia y nivel de contaminación con L. monocytogenes son muy bajas, pero permite la proliferación del microorganismo durante el almacenamiento. El helado es similar a la leche, pero no permite la proliferación de L. monocytogenes durante el almacenamiento. Los productos cárnicos fermentados están frecuentemente contaminados con listerias y su elaboración no comprende ninguna etapa listericida, pero su composición final evita la proliferación del microbio durante el almacenamiento. Tras invadir el tejido intestinal, en la mayoría de los casos L. monocytogenes se extiende a la sangre, el hígado el útero grávido, o el sistema nervioso central. Las manifestaciones de la listeriosis invasiva incluyen, pero no se limitan a, las siguientes: septicemia, infecciones del sistema nervioso central (meningitis, encefalitis, meningoencefalitis), síntomas prodrómicos en mujeres embarazadas, aborto, parto prematuro, parto de mortinato y listeriosis neonatal. Los períodos de incubación previos a la manifestación de la enfermedad pueden ser largos: normalmente, de dos a tres semanas y, en ocasiones, hasta tres meses. La listeriosis no invasiva (conocida como gastroenteritis febril por listerias) se ha observado principal-mente en algunas epidemias en las que la mayoría de los casos presentó síntomas de gastroenteritis, como diarrea, fiebre, cefalea y mialgia, tras un período de incubación corto. L. monocytogenes está distribuida ampliamente en el ambiente y se ha aislado de diversas fuentes, como tierra, vegetación, ensilados, materia fecal, agua y aguas negras. Hay indicios de que la bacteria reside transitoriamente en el tracto intestinal humano, y, según el examen de muestras fecales, son portadores del microorganismo, sin consecuencias perjudiciales para la salud aparentes, del 2 al 10% de la población general. La evaluación de riesgos muestra que la gran mayoría de los casos de listeriosis se producen como resultado del consumo de grandes cantidades de Listeria y de alimentos cuyo nivel de contaminación con el patógeno supera el límite vigente, cualquiera que fuere (0,04 o 100 UFC/g). El modelo pronostica asimismo una probabilidad baja de contraer la enfermedad tras el consumo de cantidades pequeñas de L. monocytogenes.
La probabilidad de enfermar por el consumo de un número especificado de bacterias L. monocytogenes puede representarse de forma conveniente mediante el triángulo epidemiológico, compuesto por los siguientes factores, todos importantes: la matriz alimenticia, la virulencia de la cepa y la vulnerabilidad del consumidor. Los modelos elaborados pronostican que casi todos los casos de listeriosis se originan por el consumo de concentraciones altas del patógeno. La inmensa mayoría de los casos de listeriosis está asociada al consumo de alimentos que no cumplen las normas vigentes relativas a la presencia de L. monocytogenes en alimentos, tanto si la norma estipula una tolerancia cero como si establece un límite de 100 UFC/g.
CONTROL DE ANISAKIS EN ALIMENTOS
La anisakiosis es una parasitosis que se produce en el hombre debido al consumo de pescado crudo o insuficientemente cocinado parasitado con larvas de Anisakis spp. Entre las especies más afectadas por este tipo de parásito caben destacar: bacalao, sardina, boquerón, arenque, salmón, abadejo, merluza, pescadilla, fletán, rodaballo, caballa, bonito, jurel, calamar y sepia. Las larvas de Anisakis son sensibles al calor. Se inactivan en un tiempo de 5 a 10 minutos a temperaturas superiores a 60 ° C en el centro del producto. El tiempo necesario variará en función del proceso culinario y tamaño de las piezas. En los casos que no se vayan a alcanzar estas condiciones será necesario haber realizado una congelación previa. Los productos de la pesca que vayan a ser consumidos crudos o prácticamente crudos deberán congelarse a una temperatura igual o inferior a -20°C en la totalidad del producto, durante, al menos, 24 horas, en el producto bruto o acabado.
La eficacia de la congelación depende de la temperatura y tiempo en el cual se alcanza dicha temperatura. Se recomienda que la congelación se lleve a cabo a temperatura igual o inferior a -20°C durante 7 días. La congelación no sería necesaria cuando la concentración de sal en el pescado alcance niveles superiores a 9% de ClNa y se mantenga así durante 6 semanas. En los últimos años, los enfoques “basados en los riesgos”, que tienen como fundamento la mejor información científica disponible, han sido reconocidos como medios de mejorar la capacidad de gestión de riesgos en materia de inocuidad de los alimentos para alcanzar su objetivo principal de proteger la salud pública, así como garantizar el acceso a un suministro adecuado de alimentos y facilitar el comercio. Este enfoque implica que las medidas, reglamentaciones, directrices y normas se elaboran y formulan de conformidad con un conocimiento específico de los “riesgos” para la vida y la salud. Cuando está debidamente concebida, la Evaluación de Riesgos Microbiológicos (ERM) es una evaluación objetiva y sistemática de los conocimientos científicos pertinentes que ayudan al gestor de riesgos a tomar una decisión fundamentada sobre la forma de reducir el riesgo planteado por una cuestión relativa a la inocuidad de los alimentos.
Recientemente se ha prestado particular atención a la utilización de la ERM para establecer o aplicar objetivos o parámetros microbiológicos cuantitativos basados en los riesgos, como son los objetivos de inocuidad de los alimentos (OIA), los objetivos de rendimiento (OR) y los criterios de rendimiento (CR), cuya finalidad es relacionar los objetivos de salud pública con el grado de rigor exigido por los sistemas de inocuidad de los alimentos y las medidas de control para alcanzar dichos objetivos. El Códex (Manual de procedimiento, 15ª ed.) define los tres nuevos objetivos “intermedios” siguientes:
- Objetivo de inocuidad de los alimentos (OIA): la máxima frecuencia y/o concentración de un peligro en un alimento en el momento de consumo que proporciona el nivel adecuado de protección (NAP).
- Objetivo de rendimiento (OR): la máxima frecuencia y/o concentración de un peligro en un alimento en un paso específico de la cadena alimentaria antes del momento de consumo, que proporciona o contribuye al logro de un OIA o NAP, según corresponda.
- Criterio de rendimiento (CR): el efecto que debe ser logrado en la frecuencia y/o concentración de un peligro en un alimento por medio de la aplicación de una o más medidas de control para lograr o contribuir al logro de un OR o un OIA.
Se consideró que los OIA, los OR y los CR eran objetivos intermedios, ya que constituyen un medio para vincular las medidas efectivas de control con los resultados en materia de salud pública. La gestión de riesgos no termina con la elección de medidas de control apropiadas. Debe ir seguida de actividades de vigilancia para determinar el nivel de cumplimiento. Las medidas de gestión basadas en los riesgos, cuya finalidad es lograr un nivel de protección de la salud que se pueda explicar y validar en términos de “riesgos” para la salud humana, pueden a su vez expresarse en términos de un objetivo de salud pública, del nivel adecuado de protección (NAP) alcanzado o de otros términos pertinentes. Una gestión satisfactoria de la inocuidad de los alimentos reconoce la importancia de la colaboración entre sectores interesados, y unos sistemas de gestión basados en los riesgos bien concebidos facilitan el mecanismo para dicha colaboración.
Es el funcionamiento del sistema de gestión de la inocuidad de los alimentos, tanto en términos del rigor que se pretende conseguir como del grado de coherencia con que se aplica, lo que determina la magnitud del control de un peligro logrado y, en consecuencia, el riesgo asociado con el producto final. El nivel de peligro en el momento del consumo es un determinante básico del riesgo para los consumido-res, tanto si se expresa a nivel de una población como por ración. El riesgo para la salud pública se puede cuantificar basándose en el conocimiento de la relación entre la dosis del peligro y sus efectos sobre la salud de los consumidores. Fundamentar los enfoques de gestión de la inocuidad de los alimentos en principios científicos significa que las decisiones, medidas, reglamentaciones y normas están basadas en informaciones científicas y técnicas objetivas, fiables y verificables, combinadas con datos sólidos y el dictamen o asesoramiento científico de expertos competentes. Una ERM es una evaluación objetiva y sistemática de los conocimientos científicos pertinentes que ayuda al gestor de riesgos a tomar decisiones fundadas sobre la forma de reducir los riesgos que plantea una cuestión de inocuidad de los alimentos. Es una herramienta particularmente útil para que el gestor de riesgos pueda analizar y comparar las opciones de gestión e inferir medidas de control de la inocuidad de los alimentos. Mientras que los programas de gestión de riesgos a nivel nacional se elaboran teniendo en cuenta la situación general de la totalidad de un determinado producto alimenticio consumido en un país, la aplicación efectiva de las intervenciones tiene lugar al nivel de empresas o productores, que pueden contribuir en mayor o menor medida al nivel de riesgo general en un país. El indicador de salud pública más utilizado para cuantificar los efectos de las enfermedades transmitidas por los alimentos sobre una población es la incidencia (notificada) de una enfermedad.
La incidencia de las enfermedades transmitidas por los alimentos es la suma de todos los casos de enfermedades correspondientes a todas las categorías de alimentos. Para controlar mejor las enfermedades transmitidas por los alimentos, los gestores de riesgos necesitan conocer los efectos sobre la salud pública y la contribución relativa de las posibles procedencias y vías de exposición. El proceso de definición de esta contribución relativa se denomina a menudo “atribución de la procedencia”. El gestor de riesgos puede utilizar las evaluaciones económicas para ponderar qué opciones de gestión de riesgos proporcionan el nivel de control necesario en relación a los costos y beneficios para las partes interesadas. El examen de las estrategias de gestión de riesgos y de las medidas de inocuidad de los alimentos es necesario para evaluar si todas ellas, o una en particular, logran los resultados deseados y contribuyen adecuadamente a la protección de los consumidores. Las opciones de gestión de riesgos elegidas para influir en los efectos sobre la salud pública, tanto si se necesita un cambio normativo como si no, mejoran cuando se establece una estrategia de aplicación para medir la eficacia de dichas opciones. En algunos casos, si la salud pública no mejora como consecuencia de una acción de gestión de riesgos, hay que modificar la opción, incluida la estrategia de aplicación. Una mejora de la aplicación o de la educación permite resolver el problema y la ERM puede revaluarse si los efectos sobre la salud pública no son los deseados.
"SOMOS LO QUE HACEMOS REPETIDAMENTE. EXCELENCIA, POR LO TANTO, NO ES UN ACTO SINO UN HÁBITO"
ARISTOTELES
LEGALES: El autor no asume responsabilidad alguna por la descarga, copia, distribución, modificación o alteración de los contenidos publicados, sean propios del mismo o de terceros, los cuales pudieren estar protegidos por Copyright, Derechos de Propiedad Intelectual, Derechos de Autor, o relacionados. La bibliografía general de los temas expuestos, así como todos los créditos fotográficos, están en poder del Autor y no se publican dada su extensión, pero se enviarán por mail a los interesados que los solicitaren con nota personal debidamente fundamentada.